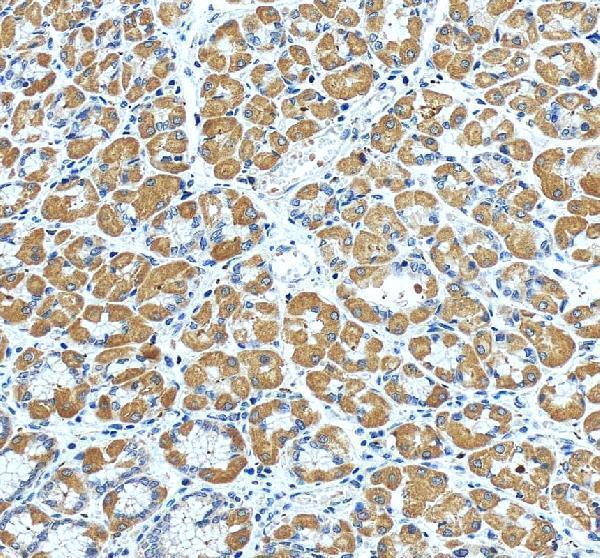
pb9320 prkce primary antibodies ihc testing 5

Product Info Summary
| SKU: | PB9320 |
|---|---|
| Size: | 100 μg/vial |
| Reactive Species: | Human, Mouse, Rat |
| Host: | Rabbit |
| Application: | IHC, WB |
Customers Who Bought This Also Bought
Product info
Product Name
Anti-PKC epsilon/PRKCE Antibody Picoband®
SKU/Catalog Number
PB9320
Size
100 μg/vial
Form
Lyophilized
Description
Boster Bio Anti-PKC epsilon/PRKCE Antibody Picoband® catalog # PB9320. Tested in IHC, WB applications. This antibody reacts with Human, Mouse, Rat. The brand Picoband indicates this is a premium antibody that guarantees superior quality, high affinity, and strong signals with minimal background in Western blot applications. Only our best-performing antibodies are designated as Picoband, ensuring unmatched performance.
Storage & Handling
Store at -20˚C for one year from date of receipt. After reconstitution, at 4˚C for one month. It can also be aliquotted and stored frozen at -20˚C for six months. Avoid repeated freeze-thaw cycles.
Cite This Product
Anti-PKC epsilon/PRKCE Antibody Picoband® (Boster Biological Technology, Pleasanton CA, USA, Catalog # PB9320)
Host
Rabbit
Contents
Each vial contains antibody formulated with stabilizing components, 0.9 mg NaCl, 0.2 mg Na2HPO4, and 0.05 mg NaN3.
*This antibody is supplied in a stabilized formulation.
Compatibility with conjugation reactions depends on the chemistry of the conjugation method used.
For conjugation methods that are not compatible with the stabilizing components present in this formulation, a carrier-free antibody format is required.
Clonality
Polyclonal
Isotype
Rabbit IgG
Immunogen
E.coli-derived human PKC epsilon recombinant protein (Position: Q53-R236). Human PKC epsilon shares 99% amino acid (aa) sequence identity with both mouse and rat PKC epsilon.
Cross-reactivity
No cross-reactivity with other proteins
Reactive Species
PB9320 is reactive to PRKCE in Human, Mouse, Rat
Observed Molecular Weight
88 kDa
Calculated molecular weight
83.7 kDa
Background of PRKCE
Protein kinase C epsilon type, also known as PKCE, is an enzyme that in humans is encoded by the PRKCE gene. The protein encoded by this gene is one of the PKC family members. PRKCE is mapped to 2p21. This kinase has been shown to be involved in many different cellular functions, such as apoptosis, cardioprotection from ischemia, heat shock response, as well as insulin exocytosis. It has been found that activation of PRKCE can induce VR1 channel activity at room temperature in the absence of any other agonist. PRKCE gene plays a role in apoptosis signaling pathways in thyroid cells and it has been indicated that a naturally occurring PRKCE mutant that functions as a dominant negative can block cell death triggered by a variety of stimuli. Expression of PRKCE inhibits chemotherapy-induced caspase-3 activation and apoptosis, thereby leading to cell survival.
Antibody Validation
Boster validates all antibodies on WB, IHC, ICC, Immunofluorescence, and ELISA with known positive control and negative samples to ensure specificity and high affinity, including thorough antibody incubations.
Application & Images
Applications
PB9320 is guaranteed for IHC, WB Boster Guarantee
Recommend Dilution
| Application | Dilution | Species |
|---|---|---|
| Immunohistochemistry (Paraffin-embedded Section) | 0.5-1μg/ml | Mouse, Rat, Human |
| Western blot | 0.1-0.5μg/ml | Human, Mouse, Rat |
Tested application
Suggested blocking solution with 5% non-fat milk or BSA; (*)Recommended protein loading: 20-40 µg per lane
Use TE buffer pH 9.0 for antigen retrieval; (*) citrate buffer pH 6.0 is an alternative.
Validation Images & Assay Conditions

Click image to see more details
Anti-PKC epsilon Picoband antibody, PB9320, Western blotting
All lanes: Anti PKC epsilon (PB9320) at 0.5ug/ml
Lane 1: Rat Brain Tissue Lysate at 50ug
Lane 2: Mosue Brain Tissue Lysate at 50ug
Lane 3: MCF-7 Whole Cell Lysate at 40ug
Predicted bind size: 88KD
Observed bind size: 88KD

Click image to see more details
Anti-PKC epsilon Picoband antibody, PB9320, IHC(P)
IHC(P): Mouse Intestine Tissue

Click image to see more details
Anti-PKC epsilon Picoband antibody, PB9320, IHC(P)
IHC(P): Rat Intestine Tissue

Click image to see more details
IHC analysis of PKC Epsilon/PRKCE using anti-PKC Epsilon/PRKCE antibody (PB9320).
PKC Epsilon/PRKCE was detected in a paraffin-embedded section of human brain tissue. Heat mediated antigen retrieval was performed in EDTA buffer (pH 8.0, epitope retrieval solution). The tissue section was blocked with 10% goat serum. The tissue section was then incubated with 2 μg/ml rabbit anti-PKC Epsilon/PRKCE Antibody (PB9320) overnight at 4°C. Peroxidase Conjugated Goat Anti-rabbit IgG was used as secondary antibody and incubated for 30 minutes at 37°C. The tissue section was developed using HRP Conjugated Rabbit IgG Super Vision Assay Kit (Catalog # SV0002) with DAB as the chromogen.
Click image to see more details
IHC analysis of PKC Epsilon/PRKCE using anti-PKC Epsilon/PRKCE antibody (PB9320).
PKC Epsilon/PRKCE was detected in a paraffin-embedded section of human stomach tissue. Heat mediated antigen retrieval was performed in EDTA buffer (pH 8.0, epitope retrieval solution). The tissue section was blocked with 10% goat serum. The tissue section was then incubated with 2 μg/ml rabbit anti-PKC Epsilon/PRKCE Antibody (PB9320) overnight at 4°C. Peroxidase Conjugated Goat Anti-rabbit IgG was used as secondary antibody and incubated for 30 minutes at 37°C. The tissue section was developed using HRP Conjugated Rabbit IgG Super Vision Assay Kit (Catalog # SV0002) with DAB as the chromogen.

Click image to see more details
The effect of SNN on SOCS3 and PKC ε expression in the liver. Male Wistar rats (6 weeks old) were placed on chow diet or HC diet for 8 weeks followed by the 4-week SNN intervention. Livers were collected, the protein expression of SOCS3 and PKCε was analysed by Western blots. Data (mean ± SE) are presented as relative expression levels compared to that of control group. ** P < 0.01 relative to control group, # P < 0.05 in comparison to HC group.
Index in PubMed under a CC BY license. PMID: 25160038
Specific Publications For Anti-PKC epsilon/PRKCE Antibody Picoband® (PB9320)
Loading publications
Recommended Resources
Here are featured tools and databases that you might find useful.
- Boster's Pathways Library
- Protein Databases
- Bioscience Research Protocol Resources
- Data Processing & Analysis Software
- Photo Editing Software
- Scientific Literature Resources
- Research Paper Management Tools
- Molecular Biology Software
- Primer Design Tools
- Bioinformatics Tools
- Phylogenetic Tree Analysis
Customer Reviews
Have you used Anti-PKC epsilon/PRKCE Antibody Picoband®?
Share your experimental results or join a short interview to earn up to $1,000 in product credits or other rewards.
0 Reviews For Anti-PKC epsilon/PRKCE Antibody Picoband®
Customer Q&As
Have a question?
Find answers in Q&As, reviews.
Can't find your answer?
Submit your question
1 Customer Q&As for Anti-PKC epsilon/PRKCE Antibody Picoband®
Question
We are currently using anti-PKC epsilon/PRKCE antibody PB9320 for mouse tissue, and we are well pleased with the WB results. The species of reactivity given in the datasheet says human, mouse, rat. Is it true that the antibody can work on primate tissues as well?
Verified Customer
Verified customer
Asked: 2017-10-09
Answer
The anti-PKC epsilon/PRKCE antibody (PB9320) has not been tested for cross reactivity specifically with primate tissues, but there is a good chance of cross reactivity. We have an innovator award program that if you test this antibody and show it works in primate you can get your next antibody for free. Please contact me if I can help you with anything.
Boster Scientific Support
Answered: 2017-10-09





